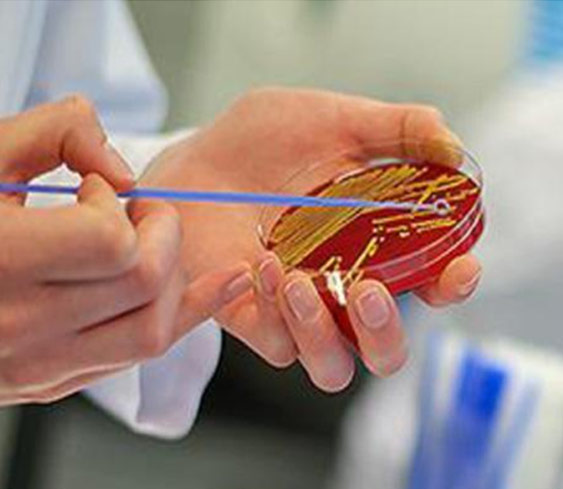
hemp-bg
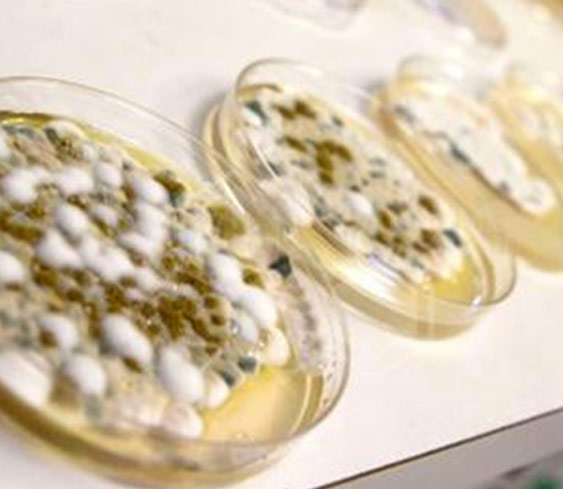
hemp

MMJ BioPharma Labs will offer a variety of services to help DEA registered producers to ensure the safety and quality of their medical marijuana products
As the federally legal medical marijuana community continues to expand throughout the United States, so too has the need for quality control/quality assurance testing services increased
Quality of Analytical Testing. The quality of any results from analytical testing are inherently tied to several factors:
The analyst performing the testing:
- Education level and experience appropriate for the testing being performed
- Training for specific analytical techniques and procedures used
- Personal integrity of the analyst
The instrumentation used for analysis:
- Quality of the instrumentation
- Proper calibration, and maintenance of instrumentation
- Adherence to strict qualification (IQ/OQ/PQ) procedures to insure proper operation of the equipment
The procedure used for testing:
- Clear and concise protocols for specified testing
- Robust, accurate, and precise validated methodologies to ensure quality results
- Adherence to current Pharmacopoeia (i.e., USP, BP, Ph.Eur., etc.)
The laboratory where testing is performed:
- Laboratory regulatory accreditation Establishment Licence, Maintenance of documentation to demonstrate:
- Competence level and training records for staff
- Procedural compliance for all instrument calibration and analytical testing
- Ability to track analytical testing results
- Integrity of the laboratory
The best way to ensure the above criteria are met is for any testing performed to be done so under Good Laboratory and Manufacturing practices. It requires the strict adherence to policies rich in documentation and record keeping
Our Advantage
MMJ BioPharma Labs will utilize the latest technology and established compendia and in-house validated methods to provide a full spectrum of Quality Assurance/ Quality Control analysis for cannabis, consisting of; (I) quantitative cannabinoid analysis (i.e., potency and profiling), (II) analysis of the essential oils to provide an aromatic profile (i.e., terpenes), (III) analysis of pesticide residue, (IV) analysis of possible contamination (i.e., heavy metals/trace element), (V) analysis of microbial contamination with fungi and bacteria, and (VI) determination of residual solvents.
Offerings for cannabis testing will include:
- Physical Identity and Foreign Matter Inspection
- Moisture Determination
- Cannabinoid Profiling and Potency Determination by High Pressure Liquid Chromatography (HPLC)
- Determination of Aflatoxin B1, B2, G1, and G2 by High Pressure Liquid Chromatography (HPLC) Ph.Eur. (current ed.) 2.8.18
- Heavy Metals Elemental Analysis
- Microbial Screening of Medical Marijuana
- Pesticide Screening: (Absent)
- Residual Solvents Analysis for Medical Marijuana Concentrates
- Terpenes Profiling
- Cannabis Sample Delivery and Sample Preparation Procedures for Analysis
Physical Identity and Foreign Matter Inspection
Morphological characteristics and variation in color of cannabis plants are influenced by the seed strain as well as by environmental factors such as light, water, nutrients and space
Dried and milled Cannabis sativa is dark green to light green and tan colored flowering heads and plant particulates with characteristic aroma having citrus and pine overtones.
Visual inspection should confirm the absence of stalks, extraneous substances, insects and other vermin.
There is no requirement to mill or irradiate the dried marihuana, although the licensed producers may choose to do so.

Moisture Determination
by Loss on Drying (LOD), USP <731>
Beginning with dry-weight determination, we analyze the percentage of water contained in each sample to confirm proper preparation during the curing process.
At MMJ BioPharma Labs we will utilize fully calibrated Mettler Toledo halogen drying moisture balances for determining moisture content in lab cannabis samples to obtain accurate and reliable moisture determination results to the fourth decimal point.
Moisture Analysis is also required for Cannabinoid potency determination and profiling of cannabis samples.
Cannabinoid Profiling and Potency Determination by High Pressure Liquid Chromatography (HPLC)
Cannabinoids occur naturally in significant quantity in the cannabis plant, and are concentrated in a viscous resin that is produced in glandular structures known as “Trichomes”.
The healthcare industry could not exist without a method to accurately dose medicine. In the case of the Cannabis plant their active ingredients are known as Cannabinoids. There are many identified cannabinoids. Of these Cannabinoids the most known active in the medical research are Δ9-tetrahydrocannabinol (Δ9-THC); Cannabidiol (CBD); acid forms of Δ9-THC (Δ9-THCA) and CBD (CBDA), Cannabichromene (CBC); Cannabigerol (CBG); Δ8 - tetrahydrocannabinol (Δ8-THC); and the degradation product of Δ9-THC, cannabinol (CBN).
Cannabinoid profiling (potency) testing via high pressure liquid chromatography is highly recommended for products that will be ingested in a raw or unheated form, infused products, and for concentrate producers looking to test the completeness of their decarboxylation process. This method uses solvents rather than heat during the analysis, allowing for detection of non-psychoactive, acidic Cannabinoids like Δ9-THCA, CBDA, and CBGA, which form Δ9-THC, CBD and CBG when heated.

At MMJ BioPharma Labs we will accurately perform potency determination/quantification and profiling of 9 cannabinoids; THCV, CBD, CBG, CBDA, CBN, Δ9-THC, Δ8-THC, CBC and Δ9-THCA using in-house validated HPLC methods.

Determination of Aflatoxin B1, B2, G1, and G2 by High Pressure Liquid Chromatography (HPLC)
Aflatoxins, a mold largely produced by Aspergillus flavus and Aspergillus parasiticus are commonly tested mycotoxins found naturally in a wide range of agriculture crops including cannabis. Due to their harmful effects on human health, animal health, and global trade, aflatoxins are regulated in most countries and have established global limits in a wide variety of matrices. Testing may often reveal aflatoxin levels above the maximum limits allowed, creating a trade restriction for certain agriculture and food products from certain countries. The tests will be performed according to their sampling methods and the results are measured against their established limits.
At MMJ BioPharma Labs we will use a validated method, based on the current accepted practices for detecting and quantifying aflatoxins.
Heavy Metals Elemental Analysis
Herbal medicines are likely to be contaminated with heavy metals. In trace amounts some heavy metals are essential for the human body however they may be toxic if present in a higher concentration. They have the ability to bio-accumulate and disrupt functions of vital organs and glands in the human body such as brain, kidney and liver.
The high concentration of heavy metals in soils is reflected by higher concentrations of metals in plants, and consequently in animal and human bodies. The uptake mechanism is selective, plants preferentially acquiring some metals over others.
At MMJ BioPharma Labs we will use the current United States Pharmacopeia USP <233> method for determination of Heavy metals in dried marihuana.
We will utilize state-of-the-art fully qualified and calibrated Iinductively Coupled Plasma mass spectrometry (ICP-MS) to identifying and quantifying the levels of Arsenic (As), Lead (Pb), Cadmium (Cd), and Mercury (Hg) present in the cannabis samples.

Microbial Screening of Medical Marijuana
Patients with serious health conditions, such as immune disorders cannot afford to be breathing in mold spores and nasty bio-toxins. As well, smoking moldy cannabis introduces spores into the lungs where they grow into large mold balls causing infection that is difficult to remedy and sometimes surgery is the only solution.
Under regulatory requirements it is the Must that Medical Marijuana be screened for mold, certain bacteria, mycotoxins (fungus metabolites), and fungus. The microbial and chemical contaminants of dried marijuana Must be within generally accepted tolerance limits for herbal medicines for human consumption, as established in any publication referred to in Schedule B of the Food and Drugs Act
Gross mold infestation is often easy to spot. Trichomes are the crystal resin factories (biosynthesize THC, Terpenes).
The resin can be confused with mold. Mold grows on top of the trichomes and looks furry cotton candy under a magnifying glass. Trichomes look nothing like cotton candy; they are "clean" looking kind of like a glass fiber optic material.
Molds are ubiquitous, and small amounts are found in almost every cannabis sample. However, exposure to high levels of such microorganisms are known to cause health problems and can be particularly dangerous to patients that have existing medical conditions.
Mold concerns in marihuana are almost always due to moisture lock. If marihuana is packaged or cured in air-tight containers while buds are moist, this creates the ideal environment to incubate, or cultivate mold and microbes.
Pesticide Screening:
Adherence to Good Production Practices:
Chemical pesticides are, by design are highly toxic and persistent. Many kill on contact and remain active for weeks, months, and even years. Human exposure to pesticides may lead to acute health problems, such as abdominal pain, dizziness, headaches, nausea, vomiting, as well as skin and eye problems. Many serious diseases, such as cancer, reproductive dysfunction, and asthma have been linked to pesticide exposure. While many growers and collective dispensaries take care to provide safe, effective products, still there are numerous reports of the presence of pesticides in purchased cannabis
MMJ BioPharma Labs will offer pesticide residue screening for the pesticides such as:
- Abamectin
- Bifenazate
- Bifenthrin
- Carbaryl
- Diazinon
- Cypermethrin
- Myclobutanil
- Paclobutrazol
- Permethrin
- Resmethrin

Residual Solvents Analysis for Medical Marijuana Concentrates
Cannabis concentrates can physically be produced in many different ways and some of these production techniques may use chemical solvents.

The presence of solvent residues within concentrated cannabis could have a significant negative impact on the health of those consuming the product. Dietary supplements, and other botanical products, provided to the general public are required to demonstrate the absence of residual solvents if any solvent was used in their production process. Medical cannabis concentrate producers should seek to establish their products are free and clean of solvents as well.
- Ethanol (alcohol)
- Isopropanol (IPA, 2-propanol)
- Methanol
- Methylene Chloride (Dichloromethane)
- Acetone
- Isobutane
- Butane
- n-Pentane
- n-Hexane
- n-Heptane
Not only can we confirm if a solvent has been used, but we will also be able to determine which solvent was used. Our method is selective and can detect trace amounts of any solvent that might have been used in cannabis concentrates production.

Terpenes Profiling
The cannabis plant consists of a wide variety of chemicals and compounds. About 140 of these belong to a large class of aromatic organic hydrocarbons known as Terpenes and Terpenoids. The terms are increasingly used interchangeably however, these terms do have different meanings. The main difference between terpenes and terpenoids is that terpenes are hydrocarbons (meaning the only elements present are carbon and hydrogen); whereas, terpenoids have been denatured by oxidation (drying and curing the flowers) or chemically modified. Cannabis age, maturation, and time of day can affect the amount and ratios of terpenes. They are constantly being produced but are vaporized by heat and light of the day.
Disclaimer: Please note MMJ BioPharma Labs is approved for a DEA Schedule 1 Analytical License. We are not lawyers and do not provide legal advice in any way shape or form. Our information is simply a summary of literature review and of services we will perform on the subject of concentrated cannabis products. If you are going to consider producing a concentrated form of medical cannabis, please properly inform yourself on all of the safety considerations of your chosen method, and seek out expert and formal legal advice on whether you can perform your chosen method legally or not.



